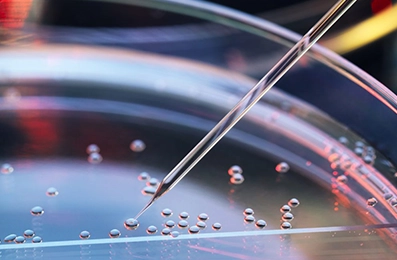

Advanced, USA Sourced Stem Cell Therapies for Clinical Use
Advanced, USA Sourced Stem Cell Therapies for Clinical Use
Regen Cell Solutions provides clinicians with access to ethically harvested, high quality, USA sourced stem cell products designed to support regenerative and neurological care.
Regen Cell Solutions provides clinicians with access to ethically harvested, high quality, USA sourced stem cell products designed to support regenerative and neurological care.
Regenerative Solutions
Why Choose Regen Cell Solutions
Why Choose
Regen Cell Solutions
Your Portal. Your Protocol. Better care.

USA-Sourced Materials.
All stem cells and exosomes are sourced from U.S. American Citizens, emphasizing safety, traceability, and regulatory alignment.
Secure Provider Portal.
A clinician-first ordering experience with streamlined documentation, fulfillment tracking, and secure access for providers
Clinical Versatility.
A regenerative and neurological treatment toolkit supporting broad indications—including Neuro Care Pro and Brain Tap
Quality & Compliance.
Processed under FDA-regulated, GMP-compliant standards with ISO clean rooms (7/6) and aligned with NMDP/Be The Match, WMDA, and AABB expectations.
The Complete Regenerative Medicine Platform
Regen Cell Solutions delivers a secure, provider-first platform for sourcing high-quality stem cells and exosomes with complete transparency and control. All materials are USA sourced and processed under strict FDA regulated, GMP compliant conditions, ensuring safety, traceability, and clinical confidence.
USA Sourced Materials
All stem cells collected from U.S. residents (USA).
Provider Centric Portal
A secure, integrated ordering portal for sourcing, documentation, and fulfillment.
Clinical Versatility
A portfolio that supports a broad range of indications, including neurological and regenerative therapies.
Quality & Safety
FDA-regulated, GMP-compliant processing; ISO-clean rooms; NMDP/Be The Match, WMDA, and AABB standards.
Patient Modalities
Neuro Care Pro and Brain Tap as part of our treatment options.